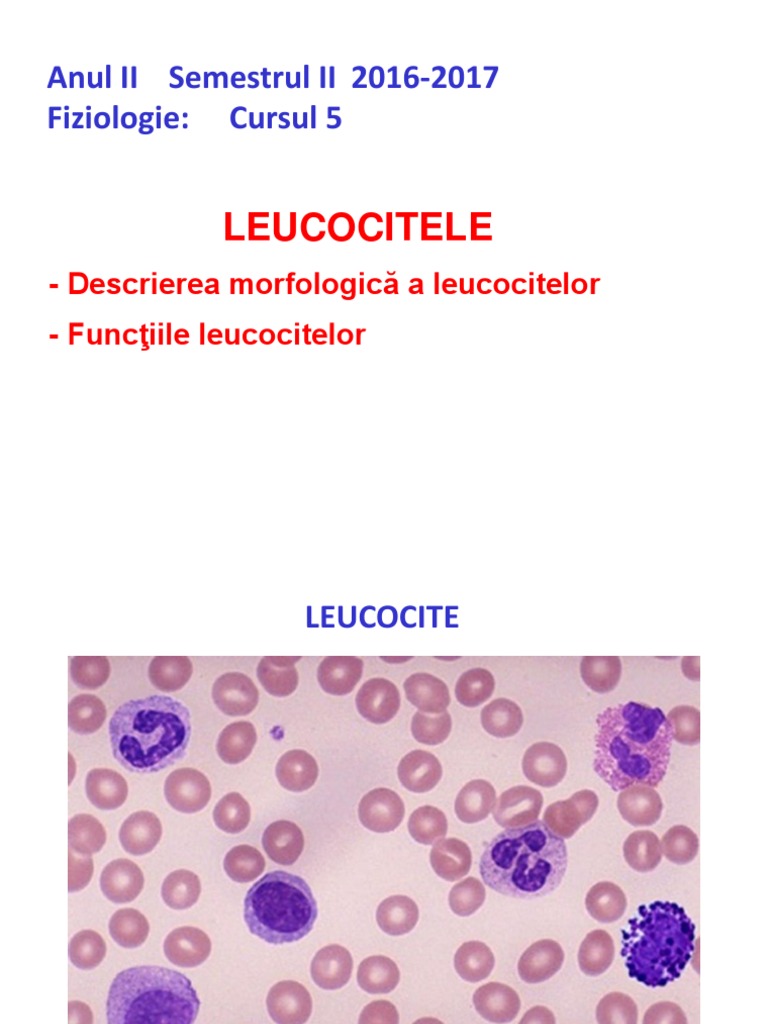

Leucocite Frecvente In Secretie

Celule epiteliale poligonale numeroase leucocite frecvente trichomonas vaginalis absent levuri frecvente inmugurite absente hife pseudohife prezente flora bacteriana flora bacteriana frecventa.
Leucocite frecvente in secretie. Un diagnostic corect urmat de un tratament bine ales şi corect condus în paralel cu explicarea clară a regulilor minime de igienă genitală şi sexuală au consecinţe favorabile pe termen lung în special la segmentul tânăr al populaţiei feminine care este de altfel cel mai. La urina leucocite relativ frecvente celule epiteliale rare flora microbiana relativ frecventa leucocitele 75 in condotia in care val normala ar trebui sa fie negativa ac ascorbic 20mg uric 2 29 la hematologie mo 2 8 pdws 21 5 rdws 31 6 astept un raspuns multumesc anticipat. Secretie vaginala din comunitate. Examen microscopic leucocite frecvente celule epiteliale foarte numeroase numeroasa flora doderlein.
Leucocite 4 2 vn 4 0 10 0. Nu spun k e vorba despre e coli spun doar cazul cel mai frecvent. Leucocite relative frecvente. Examen microscopic colorat secretie frotiu colorat gram din secretie vaginala.
Sunt insarcinata in 19 sapt si la ultimul examen al secretiei vaginale mi a iesit urmatorul rezultat frotiu coloratia gram celule epiteliale relativ frecvente leucocite relativ frecvente detritus flora gram pozitiva rari coci flora gram negativa frcventi cocobacili si bacili fini fungi prezenti spori inmuguriti trichomonas vaginalis absent asistenta a spus ca. Leucocite relativ frecvente secțiunea. Celule epiteliale relativ frecvente leucocite absente flora microbiana cu rari bacili gram pozitivi rari coci gram pozitivi izolati si in diplo levuri absente trichomonas vaginalis. A coci gram pozitivi in perechi si lanturi scurte.
Infecţiile genitale reprezintă una din cele mai frecvente motive de prezentare la medicul ginecolog. Examen citobacteriologic secretie vaginala ex. Frecvent bacilli scurti gram labili. Examen microscopic secretie vaginala.
Leucocite 0 mm cub bacterioscopie negativa culturi 1000 ufc ml hematologie. Frecvente leucocite infectie bacili gram negativi e coli etc. Celulele epiteliale plate rare leucocite rare eritrocite rare flora bacteriana numeroasa urocultura. Absenti lactobacili flora abundenta mixta cocobacili gram variabili gardnerella like.
E posibil sa fie vorba despre o infectie urinara e coli e agent etiologic al infectiilor urinare in 80 din cazuri. în ce caz este rezonabilă efectuarea frotiului bacteriologic din vagin. Flora lactobacilara rara. Prezenta crestere bacteriana culture cu incubare in aerobioza.
Ghid argumentat științific pentru femei cu privire la interpretarea rezultatelor frotiului vaginal și la pregătirea pentru această analiză. Forum medical in urma carora am primit urmatoarele rezultate. Pmn flora de tip 3 rare epitelii foarte rari lactobacili frecventi bacili gram negativi coci gram negativi și pozitivi frecvente polimorfonucleare flora de tip 4. Microscopic inapoi la glosar.
Celule epiteliale frecvente. Ce semnificație are ph ul secrețiilor vaginale frotiul bacteriologic testul cu koh prezența tricomonadelor a gonococilor a leucocitelor a fungilor a mucusului a.